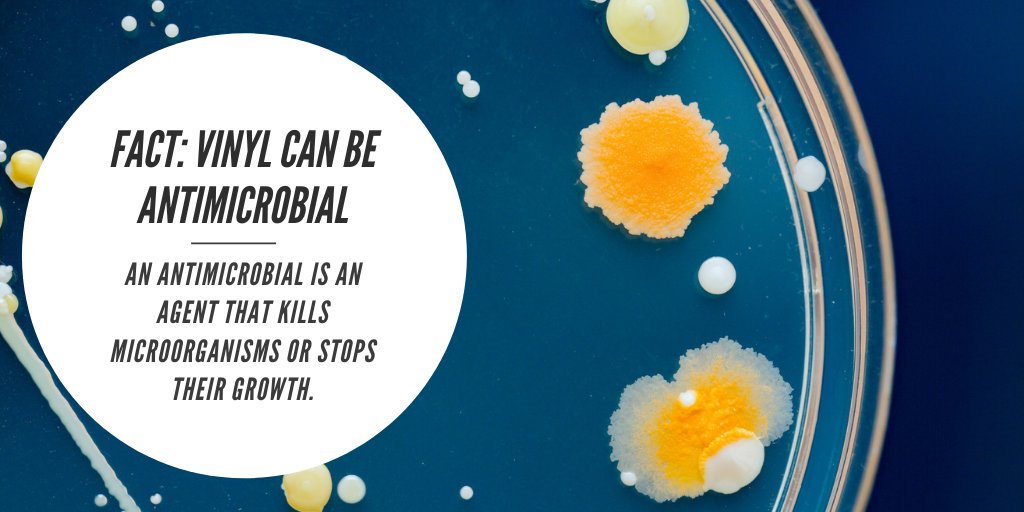
vinylinstitute's tweet image. #PVC has been the material of choice in providing protection throughout the current #pandemic. 

It is a durable, easy to disinfect, and low-cost material.

AAPVC
@AAPVC
Entidad que reúne a las grandes, medianas y pequeñas empresas relacionadas con la industria del Policloruro de Vinilo 🔁
You might like
¡Conocé a nuestros socios! Desde la AAPVC trabajamos en pos del beneficio de nuestros asociados y la industria del PVC. #aapvc #pvc



¡Feliz día de los trabajadores y trabajadoras! 👏 Hoy queremos saludar a todas las personas que día a día aportan su granito de arena a fin de potenciar el desarrollo de la industria en nuestro país. ¡Feliz día, especialmente a nuestros socios! 🤝

Realizamos la primera reunión de la Comisión Directiva de la AAPVC. La reunión fue rica en aportes por parte de los socios presentes, quienes acordaron que 2023 es un año de cambios y desafios. ¡Nos espera un gran año de trabajo junto a nuestros socios! 💪🏽

¿Sabías que los zócalos de PVC de Tecnoperfiles contribuyen a la economía circular? Conocé cómo acá: shorturl.at/COZ07

¡Feliz día de la madre y la familia! En especial a quienes son parte de nuestra Asociación. 💙

If camping’s not your thing, maybe “Glamping” is! These vinyl dwellings can be easily erected to help elevate the traditional camping experience. Feel more than just one with the dirt & enjoy mother nature’s views from the safe, dry & sanitary atmosphere of your #vinyl globe.



🇦🇷 Hoy celebramos 206 años de nuestra querida Patria. 🇦🇷 ¡Feliz día de la Independencia Argentina!

La Asociación Argentina del PVC auspicia BATEV 2022, exposición líder de la construcción y la vivienda, que se realizará de manera presencial luego de 3 años. 👉🏼 Acercate al stand B38, ¡Te esperamos! Invitación sin cargo acreditándote en batev.com.ar

📌¿Todavía no te sumaste? Curso para Colegios de Arquitectos: Materiales de PVC para la construcción. Introducite en el mundo de la arquitectura y el diseño a partir del uso de uno de los materiales predilectos en el sector de la construcción. + info: aapvc.org.ar

Vinyl options aren’t just limited to siding! If you are looking for a unique floor pattern try cutting square vinyl flooring diagonally. The possibilities are endless when it comes to #vinyl and your home!

Nice post!
Did you know that about 85% of #PVC is used for products that last anywhere from 15 to 100 years? In other words, PVC innovations can continue to make a difference decades after their creation. Create your legacy of #sustainability with a career in the vinyl industry.
¡Vuelve la Expo Construir de manera presencial! Desde la AAPVC acompañamos el regreso de este evento clave para el mercado, en el que se brindará una visión estratégica y las principales innovaciones de la construcción. Más info: expoconstruir.com

Few other materials can bring us music, shelter, healthcare, AND water — but vinyl can! It plays a huge role in almost everyone’s lives, composing windows, doors, and siding, recording songs, creating medical devices, and strengthening our plumbing.

Great article from @BldngEnclosure and the Chemical Fabrics & Film Association! PVC is a great choice for #roofing because of its heat-welded seams, combustion resistance, water tightness, and wind uplift rating. #Vinyl bit.ly/3HErPHU
buildingenclosureonline.com
Why Are PVC Roofs So Durable?
How durable is PVC roofing? So durable that it was chosen for the National Oceanic and Atmospheric Administration’s Hurricane Center located in Miami. This is an organization that knows a thing or...
¡Por un nuevo año colmado de satisfacciones! ¡Deseamos un muy feliz 2022! ✨

With their non-porous surface, #vinyl #faceshields make it hard for germs to congregate & multiply. They are easily sanitized & provide an additional barrier meant to protect against #COVID19. That’s why doctors love them.

#PVC has been the material of choice in providing protection throughout the current #pandemic. It is a durable, easy to disinfect, and low-cost material.
When your hospital signs up for the #PVC123 Medical Recycling program you’re showing the environment a little love! This program helps to reduce landfill waste, & keep this valuable material in the economy.

United States Trends
- 1. #MeAndTheeSeriesFinalEP N/A
- 2. Good Saturday N/A
- 3. Taemin N/A
- 4. #OrmBlossominShanghaiEvent N/A
- 5. ORMKORN BA BLOSSOMIN N/A
- 6. Jayda N/A
- 7. #FreenFanSignInTIANJIN N/A
- 8. Michael Cohen N/A
- 9. Manchester City N/A
- 10. McBride N/A
- 11. SAROCHA AT TIANJIN EVENT N/A
- 12. Smart Money N/A
- 13. The Rip N/A
- 14. #JustinStrong N/A
- 15. #DragRace N/A
- 16. Hannity N/A
- 17. baekhyun N/A
- 18. AI Summary N/A
- 19. Gibbs N/A
- 20. Gobert N/A
You might like
-
 PVC4Pipes
PVC4Pipes
@PVC4Pipes -
 Vinyl Institute
Vinyl Institute
@vinyl_institute -
 +Vantage Vinyl™
+Vantage Vinyl™
@VantageVinyl -
 VinylPlus
VinylPlus
@VinylPlus_EU -
 VinylPlus Healthcare
VinylPlus Healthcare
@vinylplushealth -
 Beatriz Meunier
Beatriz Meunier
@beatrizmeunier1 -
 Plásticos Alser - New Polymers & Compound
Plásticos Alser - New Polymers & Compound
@PlasticosAlser -
 Circo Innovations
Circo Innovations
@Circo_PVC -
 Poly Rafia, SA de CV
Poly Rafia, SA de CV
@PolyRafiaMX -
 CelticGoddess
CelticGoddess
@writeaine
Something went wrong.
Something went wrong.


































































































